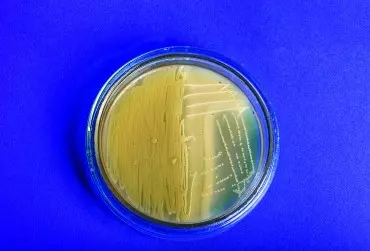

W świetle najnowszych danych, nabłonek błony śluzowej dziąsła wraz z nierozerwalnie związaną z nim społecznością ogromnej ilości komensalnych i symbiotycznych drobnoustrojów nadają zupełnie nowy wymiar niezwykle skomplikowanej komunikacji między środowiskiem zewnętrznym a komórkami ludzkiego organizmu.
Autor: Oskar Kaczmarek
Afty nawrotowe mają niezwykle złożoną etiologię, dlatego w codziennej praktyce znalezienie przyczyny ich powstawania nierzadko nastręcza wiele trudności diagnostycznych i terapeutycznych. Ponadto mimo przeprowadzonych licznych badań i opublikowanych prac naukowych poświęconych temu zagadnieniu, nadal nie dysponujemy skutecznymi środkami umożliwiającymi zarówno efektywne leczenie, jak i przede wszystkim zapobieganie nawrotom choroby. Aktualnie coraz większa grupa badaczy podkreśla fundamentalną rolę nieprawidłowej aktywacji układu immunologicznego – wyzwalanej przez szereg lokalnych i ogólnoustrojowych czynników – z towarzyszącymi zaburzeniami funkcjonalnymi mikrobioty śluzówkowej w powstawaniu wykwitów aftowych.
W świetle najnowszych danych, nabłonek błony śluzowej dziąsła wraz z nierozerwalnie związaną z nim społecznością ogromnej ilości komensalnych i symbiotycznych drobnoustrojów nadają zupełnie nowy wymiar niezwykle skomplikowanej komunikacji między środowiskiem zewnętrznym a komórkami ludzkiego organizmu.
W świetle najnowszych danych, nabłonek błony śluzowej dziąsła wraz z nierozerwalnie związaną z nim społecznością ogromnej ilości komensalnych i symbiotycznych drobnoustrojów nadają zupełnie nowy wymiar niezwykle skomplikowanej komunikacji między środowiskiem zewnętrznym a komórkami ludzkiego organizmu.
Ostatnie lata zrewolucjonizowały dotychczasowe postrzeganie znaczenia drobnoustrojów kolonizujących wszystkie błony śluzowe ludzkiego ciała. Do momentu wprowadzenia nowoczesnych technik biologii molekularnej służących do identyfikacji mikroorganizmów koncentrowano się przede wszystkim na ich właściwościach patogennych, zupełnie nie zdając sobie sprawy z drugiej strony relacji drobnoustroje–gospodarz. Biorąc pod uwagę ogromny rozkwit wiedzy w tym obszarze, relacja ta bezsprzecznie stanowi determinantę o wiele większej liczby fundamentalnych aspektów ludzkiej fizjologii, niż do tej pory sądzono.
Nasza wiedza na temat ogromnego znaczenia mikrobioty przewodu pokarmowego dla funkcjonowania praktycznie wszystkich narządów i układów ludzkiego organizmu nieustannie rośnie. Zrozumienie mechanizmów, za pomocą których drobnoustroje fizjologicznie kolonizujące błony śluzowe modulują głównymi szlakami sygnałowymi, odgrywającymi kluczową rolę w utrzymaniu ogólnoustrojowej homeostazy swojego gospodarza, spowodowało w ostatnich latach wręcz lawinowy wzrost zainteresowania ideą probiotykoterapii jako głównego działania terapeutycznego mającego na celu zoptymalizowanie funkcjonalności układu mikroekologicznego śluzówek.
W terapii zakażeń bakteryjnych istnieje obecnie bezwzględna konieczność uwzględnienia uszkodzeń w strukturze ekosystemu bakteryjnego przewodu pokarmowego, jakie coraz częściej obserwuje się jeszcze kilka lat po zakończeniu leczenia. Według statystyk European Surveillance of Antibiotic Consumption, Polska wciąż należy do czołówki krajów europejskich, w których konsekwentnie rośnie zarówno liczba ogólnie zażywanych leków przeciwbakteryjnych, jak i przypadków ich nieuzasadnionego stosowania w praktyce lekarskiej.
Afty nawrotowe mają niezwykle złożoną etiologię, dlatego w codziennej praktyce znalezienie przyczyny ich powstawania nierzadko nastręcza wiele trudności diagnostycznych i terapeutycznych. Ponadto mimo przeprowadzonych licznych badań i opublikowanych prac naukowych poświęconych temu zagadnieniu, nadal nie dysponujemy skutecznymi środkami umożliwiającymi zarówno efektywne leczenie, jak i przede wszystkim zapobieganie nawrotom choroby. Aktualnie coraz większa grupa badaczy podkreśla fundamentalną rolę nieprawidłowej aktywacji układu immunologicznego – wyzwalanej przez szereg lokalnych i ogólnoustrojowych czynników – z towarzyszącymi zaburzeniami funkcjonalnymi mikrobioty śluzówkowej w powstawaniu wykwitów aftowych.
Odkrycie pierwszego antybiotyku przez Aleksandra Fleminga na długie lata skutecznie odwróciło uwagę środowiska medycznego od koncepcji zgoła przeciwstawnej – idei bakterioterapii, o której już na początku XX wieku mówił rosyjski noblista, mikrobiolog i immunolog Ilja Miecznikow. W chwili obecnej, wraz z rozwojem badań nad strukturą i funkcją fizjologicznej mikrobioty ludzkiego organizmu, idea ta ponownie wraca do łask, a potencjał wykorzystania określonych drobnoustrojów zarówno w profilaktyce, jak i w celach terapeutycznych docenia coraz większa grupa specjalistów różnych dziedzin medycyny.
Uznanie roli środowiska mikrobiologicznego przewodu pokarmowego w etiopatogenezie wielu jednostek chorobowych, a także jego krytycznego znaczenia w modulowaniu głównymi szlakami sygnałowymi związanymi z utrzymywaniem homeostazy głównych ramion polaryzacji immunologicznej stało się podstawą do coraz szerszego wykorzystywania drobnoustrojów w celach terapeutycznych. Biorąc pod uwagę długotrwałe zaburzenia mikrobiologiczne, które obserwuje się już po 7 dniach kuracji szerokowidmowym lekiem przeciwbakteryjnym, wdrażanie działań naprawczych ukierunkowanych na optymalizację warunków panujących w jelicie jest obecnie warunkiem koniecznym skutecznej i bezpiecznej farmakoterapii. W artykule podsumowano aktualną wiedzę na temat racjonalnej probiotykoterapii w trakcie i po zakończeniu kuracji antybiotykowej, zasad doboru szczepów probiotycznych i problemów wynikających z jakości preparatów probiotycznych dostępnych na polskim rynku.
W praktyce stomatologicznej jednymi z najczęściej przepisywanych leków są antybiotyki, których stosowanie wiąże się z zaburzeniami w obrębie mikrobioty jelitowej. W związku z coraz większą wiedzą na temat jej kluczowego znaczenia dla prawidłowej odpowiedzi immunologicznej wzrasta też świadomość konieczności stosowania odpowiednich preparatów w trakcie i po antybiotykoterapii.